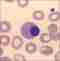

eLearning Hämatologie
Speziell für BMA und MTLA
Steigere deine Expertise mit maßgeschneiderten eLearning-Forbildungen für Labormitarbeiter.
Grundlagen der Hämatologie
Erfahre, welche Zellen welche wichtigen Aufgaben erfüllen und lerne deren Interaktion kennen.
Mikroskopische Differenzierung
Rolle der Anämien
Unser Schwerpunkt im ersten elearningkurs ist die Änämie. Welche Formen gibt es und wie werden diese diagnostiziert?
Fallbeispiele
Mehr Praxiswissen durch digitale Fortbildungen im Bereich Hämatologie
Der Kurs ist speziell auf die Bedürfnisse von BMA & MTLA zugeschnitten. Er vermittelt das notwendige Fachwissen, um die täglichen Aufgaben im Labor professionell und effizient zu bewältigen. Verständnis als Schlüssel zum eigenen Erfolg.
Grundlagen der Hämatologie
Immer wird kurz auf die Grundlagen eingegangen, der Schwerpunkt liegt aber auf dem Verständnis von Änämien.
Laborparameter
Welche Werte liefert das Blutbild? Zusammen mit der Anamnese, der körperlichen Untersuchung und den Laborwerten kann schnell reagiert werden.
Praxisnahe Fallbeispiele
Die genannten Beispiele orientieren sich vielfach an der Praxis. Situationsbeschreibungen schaffen somit mehr Nähe zum theoretischen Inhalt.
Laborparameter im Detail
Einteilung nach Morphologie, Ätiologie und Pathogenetik. Auf das Zusammenspiel kommt es an.
Anmelden und Hämatologieexperte werden
Jetzt anmelden, praxisnahes Wissen online erwerben und in der Hämatologie durchstarten.

Zielgruppe
Diese online Fortbildung richtet sich an alle Labormitarbeiter und Labormitarbeiterinnen, die ihre Kenntnisse in der Hämatologie mithilfe einer digitalen Fortbildung von BMA Alexander Riegler vertiefen möchten.
Biomedizinische Analytiker*Innen (MTA/BMA)
Eigenverantwortliches Arbeiten von BMA ist auch im Teilbereich der Hämatologie Voraussetzung für korrekte und rasche Laborwerte.
Medizinisch-technische Laborassistentinnen und Laboratoriumsassistenten (MTLA)
Fachkräfte (MTLA / MTF / MAB) für die medizinische Labordiagnostik führen nicht nur die Analysen durch, sondern haben auch ein sehr gutes Verständnis für die Hämatologie.
Mediziner*Innen und Medizinstudent*Innen
Wer einen guten Einstieg in den Teilbereich Hämatologie sucht oder sein Wissen aktualisieren möchte, der ist hier genau richtig.
Alle andere Spezialisten und Interessierte an Hämatologie
Die Hämatologie ist ein essenzieller physiologischer Ablauf im Körper. Was aber, wenn diese einmal nicht mehr so optimal abläuft?

Lernziele in der digitalen Fortbildung für Hämatologie
Verständnis der Blutbestandteile und ihrer Funktionen
- Ziel: Die Teilnehmer erlangen detaillierte Kenntnisse über Erythrozyten, Leukozyten, Thrombozyten und Plasma und deren Rolle im Körper.
- Nutzen: Mit diesem Wissen können Labormitarbeiter Blutuntersuchungen effizienter durchführen und pathologische Veränderungen frühzeitig erkennen.
Diagnostische Methoden in der Hämatologie anwenden
- Ziel: Die Teilnehmer lernen, wie verschiedene Labortests zur Analyse von Blut eingesetzt werden, z. B. Blutbilder und Differentialblutbilder.
- Nutzen: Durch praxisnahes Wissen können die Teilnehmer Laborprozesse optimieren und zur besseren Diagnosestellung beitragen.
Erkennen und Einordnen von Erkrankungen - Fokus Anämien
- Ziel: Der Kurs Hämatologie 1 vermittelt die Fähigkeit, Blutkrankheiten wie Anämien besser zu identifizieren.
- Nutzen: Die Teilnehmer verbessern ihre diagnostischen Fähigkeiten und können Krankheitsbilder schneller und sicherer interpretieren.
Therapeutische Ansätze in der Hämatologie verstehen
- Ziel: Die Teilnehmer erhalten einen Überblick über aktuelle Behandlungsmöglichkeiten wie Transfusionen oder Chemotherapien.
- Nutzen: Sie können sich fundiert an Therapieentscheidungen beteiligen und Patienteninformationen besser verständlich vermitteln.
Deine Vorteile
Vorteil 1
Flexibles Lernen
Der Kurs ist online verfügbar und kann jederzeit und überall absolviert werden, ideal für Berufstätige und Personen mit kleinen Kindern.
Vorteil 1
Vorteil 2
Praxisnähe
Reale Fallbeispiele und praxisbezogene Inhalte machen das Gelernte sofort im Berufsalltag anwendbar.
Vorteil 3
Individuelle Unterstützung
Persönliche Betreuung durch den Kursleiter per E-Mail für gezielte Fragen und schnelle Antworten.
Vorteil 3
Vorteil 4
Selbstkontrolle
Kontrollfragen am Ende jedes Abschnitts ermöglichen es den Teilnehmern, ihren Lernfortschritt kontinuierlich zu überprüfen.
eLearning Experte Alexander Riegler
Der eLearningkurs Hämatologie von Alexander Riegler auf der Plattform UDEMY für BMA und MTLA sichert auf lange Sicht deine berufliche Weiterentwicklung.
Das fundierte Wissen im Bereich der Hämatologie fördert zudem die berufliche Expertise und eröffnet neue Karrierechancen. Dem Sprecher gelingt es online, auch komplexe Inhalte einfach zu erklären. Die anschaulichen Erklärungen der theoretischen Inhalte erleichtern das Verständnis von komplexen Inhalten.
Nach dem erfolgreichen Kursbesuch erhält jeder Kursteilnehmer bzw. jede Kursteilnehmerin automatisiert ein Zertifikat. Dieses kann dem Dienstgeber vorgelegt werden, da es die erworbenen Kenntnisse bestätigt, womit dann eine persönliche Fortbildung angerechnet werden kann.